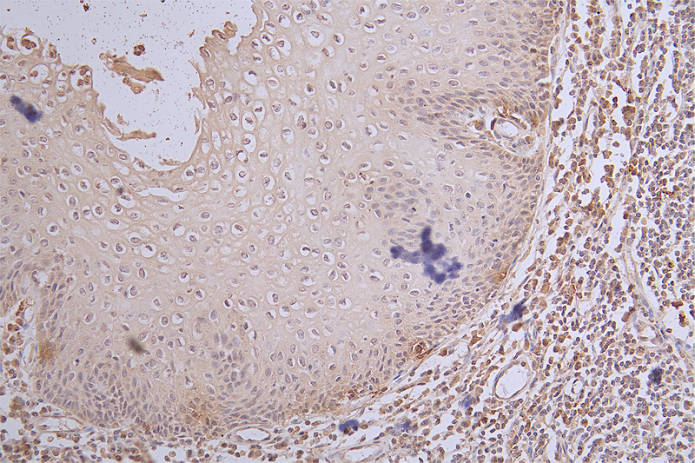

MKI67 Recombinant Monoclonal Antibody
-
中文名稱:MKI67重組抗體
-
貨號:CSB-RA984483A0HU
-
規格:¥1320
-
圖片:
-
IHC image of CSB-RA984483A0HU diluted at 1:100 and staining in paraffin-embedded human tonsil tissue performed on a Leica BondTM system. After dewaxing and hydration, antigen retrieval was mediated by high pressure in a citrate buffer (pH 6.0). Section was blocked with 10% normal goat serum 30min at RT. Then primary antibody (1% BSA) was incubated at 4°C overnight. The primary is detected by a Goat anti-rabbit polymer IgG labeled by HRP and visualized using 0.65% DAB.
-
Overlay Peak curve showing Hela cells stained with CSB-RA984483A0HU (red line) at 1:50. The cells were fixed in 4% formaldehyde and permeated by 0.2% TritonX-100. Then 10% normal goat serum to block non-specific protein-protein interactions followed by the antibody (1μg/1*106cells) for 45min at 4℃. The secondary antibody used was FITC-conjugated Goat Anti-rabbit IgG(H+L) at 1:200 dilution for 35min at 4℃.Control antibody (green line) was rabbit IgG (1μg/1*106cells) used under the same conditions. Acquisition of >10,000 events was performed.
-
-
其他:
產品詳情
-
產品描述:CSB-RA984483A0HU MKI67重組單克隆抗體是針對細胞增殖標志物Ki-67蛋白研發的高特異性科研試劑。該抗體識別的靶標MKI67基因編碼的核蛋白在細胞周期G1、S、G2和M期持續表達,但在靜止期(G0)消失,是評估細胞增殖活性的經典生物標志物。經ELISA、免疫組化(IHC)和流式細胞術(FC)等多平臺驗證,本品在推薦稀釋比例(IHC 1:50-1:200,FC 1:50-1:200)下展現出優異的檢測性能,其中IHC實驗可清晰呈現核內抗原定位,FC分析能有效識別目標抗原表達水平。適用于腫瘤組織增殖活性評估、細胞周期相關機制研究及抗腫瘤藥物體外篩選等科研領域,尤其可為癌癥病理分析、實驗模型構建及分子生物學研究提供可靠工具。本產品采用重組表達技術制備,具有高批次間一致性和低交叉反應性特點,為體外實驗數據可重復性提供保障。
-
Uniprot No.:
-
基因名:MKI67
-
別名:Proliferation marker protein Ki-67 (Antigen identified by monoclonal antibody Ki-67) (Antigen KI-67) (Antigen Ki67), MKI67
-
反應種屬:Human
-
免疫原:A synthesized peptide derived from Human MKI67
-
免疫原種屬:Homo sapiens (Human)
-
標記方式:Non-conjugated
-
克隆類型:Monoclonal
-
抗體亞型:Rabbit IgG
-
純化方式:Affinity-chromatography
-
克隆號:16H10
-
濃度:It differs from different batches. Please contact us to confirm it.
-
保存緩沖液:Rabbit IgG in 10mM phosphate buffered saline , pH 7.4, 150mM sodium chloride, 0.05% BSA, 0.02% sodium azide and 50% glycerol.
-
產品提供形式:Liquid
-
應用范圍:ELISA, IHC, FC
-
推薦稀釋比:
Application Recommended Dilution IHC 1:50-1:200 FC 1:50-1:200 -
Protocols:
-
儲存條件:Upon receipt, store at -20°C or -80°C. Avoid repeated freeze.
-
貨期:Basically, we can dispatch the products out in 1-3 working days after receiving your orders. Delivery time maybe differs from different purchasing way or location, please kindly consult your local distributors for specific delivery time.
-
用途:For Research Use Only. Not for use in diagnostic or therapeutic procedures.
相關產品
靶點詳情
-
功能:Required to maintain individual mitotic chromosomes dispersed in the cytoplasm following nuclear envelope disassembly. Associates with the surface of the mitotic chromosome, the perichromosomal layer, and covers a substantial fraction of the chromosome surface. Prevents chromosomes from collapsing into a single chromatin mass by forming a steric and electrostatic charge barrier: the protein has a high net electrical charge and acts as a surfactant, dispersing chromosomes and enabling independent chromosome motility. Binds DNA, with a preference for supercoiled DNA and AT-rich DNA. Does not contribute to the internal structure of mitotic chromosomes. May play a role in chromatin organization. It is however unclear whether it plays a direct role in chromatin organization or whether it is an indirect consequence of its function in maintaining mitotic chromosomes dispersed (Probable).
-
基因功能參考文獻:
- RAGE, EGFR and Ki-67 were immunohistochemicalyl studied for their expression in biopsy specimens from primary breast tumors PMID: 30139236
- High Ki-67 expression is associated with Central Giant Cell Granuloma. PMID: 30139237
- Our results identified FGFR3(high)/Ki67(high) papillary pTa tumors as a subgroup with poor prognosis and encourage histological grading as high grade tumors. PMID: 30154342
- PD-L1, Ki-67, and p53 staining individually had significant prognostic value for patients with stage II and III colorectal cancer PMID: 28782638
- Studies indicate that high Ki-67 expression was correlated with poor prognosis and advanced clinicopathological features, and it could serve as a biomarker for disease management [Review]. PMID: 28287186
- High Ki67, EZH2, and SMYD3 immunoexpression, adjusted for standard clinicopathological parameters, independently predicts outcome in patients with prostate cancer, at diagnosis. PMID: 29174711
- the combination of the TERT promoter/BRAFV600E mutations and Ki-67 LI is a promising marker to predict recurrence of PTC. PMID: 28150740
- p16/Ki-67 dual immunostaining had comparable sensitivity and improved specificity in screening high-grade cervical intraepithelial neoplasm (HGCIN) or CC when compared with hrHPV detection. Further studies may be beneficial to assess the efficacy of this novel biomarker, which can be potentially used as one of the initial screening assays. PMID: 30249873
- We show that it is possible to approximate the true Ki67 Index accurately without detecting individual nuclei and also statically demonstrate the weaknesses of commonly adopted approaches that use both tumor and non-tumor regions together while compensating for the latter with higher order approximations PMID: 30176814
- Prognosis of luminal breast carcinoma can be predicted using Ki67 as a continuous variable and a standard cut-off value of 14%. Information about the specimen type used to determine ki67 should be recorded in the pathological report PMID: 28865009
- Ki-67 and TOPO 2A expression correlated with tumour size and tumour invasiveness in somatotropinomas. PMID: 29334118
- The aim of this study was to investigate the expression of p16 and SATB1 proteins in regard to expression of the Ki-67 antigen and available clinicopathological data (i.a. receptor status, staging and grading PMID: 29936452
- Data suggest that Ki-67 is a strong prognostic factor for overall survival (OS) and disease-free survival (DFS) and should be included in all pancreatic neuroendocrine tumor pathology. PMID: 29351120
- Ki-67-a proliferation marker is easily identified and provides comparable accurate information. In contrast to poor reproducibility of mitotic counts, Ki-67 can achieve high agreement between pathologists; is more reproducible; adds complementary value to the MBR grading system and correlates well with other clinicopathologic parameters. PMID: 29893312
- High Ki-67 expression is associated with papillary thyroid carcinoma. PMID: 29855303
- This study demonstrated that p16/Ki-67 dual staining represents an effective method for cervical cancer screening. Application of this method could lead to a reduction of unnecessary colposcopy referrals and misdiagnosis. PMID: 29758205
- In human adenocarcinoma tissues, PFKFB3 and Ki67 protein levels were related to the clinical characteristics and overall survival PMID: 29327288
- In leukoplakia, the expression of survivin associated with that of ki-67 reinforces the assumption that all these lesions are potentially malignant. PMID: 28346726
- High Ki67 expression in the index prostate cancer lesion is an independent predictor of biochemical recurrence in patients with positive surgical margin following radical prostatectomy. PMID: 29506507
- Ki-67 expression level failed to have a markedly significant impact on survival in patients with extensive-stage small cell lung cancer PMID: 28589765
- p16/Ki-67 dual staining can increase the efficiency of screening methods for cervical cancer. PMID: 29895125
- both the value and the level of Ki-67 expression were correlated positively with the normalized iodine concentration (NIC) values (r=0.344, P=0.002 and r=0.248, P=0.026); HIF-1alpha expression was correlated positively with the NIC values of the RC (r=0.598, P<0.001) PMID: 29103468
- According to immunohistochemistry and immunoblot analysis, the expression levels of cyclin D1, cyclin E, pRb, and Ki67 in psoriasis lesions decreased after treatment and were similar with those in the normal group PMID: 29115643
- Studies suggest that Ki-67 acts as an organiser of chromosome periphery region [Review]. PMID: 28838621
- High Ki-67 immunohistochemical expression levels in distant metastatic lesions were independently associated with poorer overall survival outcomes after biopsy of recurrence lesion in breast cancer patients. PMID: 28425014
- Data show there was no trend to higher Ki-67 antigen in metastatic than primary pancreatic neuroendocrine tumors (NETs). PMID: 28984786
- Data suggest that Ki-67 antigen proliferative index has important limitations and hhosphohistone H3 (PHH3) is an alternative proliferative marker. PMID: 29040195
- A high Ki-67 LI correlated significantly with a worse prognosis in gastric cancer (GC)patients. Further cumulative studies for the optimal cutoff value for high Ki-67 LI are needed before application in clinical practice. PMID: 28561880
- Ki67 expression in gastric carcinoma is directly correlated with the tumor grade and depth of invasion. PMID: 28965621
- In ACTH-secreting pituitary tumors, Ki-67 was expressed in 7 of 28 recurrent tumors and 8 of 27 nonrecurrent tumors, and there was no staining in normal pituitary samples. It was expressed predominantly in the nucleus of the tumor cells. There was no significant difference between Ki67 expression between the nonrecurrent group and the recurrent group. PMID: 29432944
- Adjuvant chemotherapy was 9% less likely to be recommended by a multidisciplinary board when using the current criteria compared with using a combination of the St. Gallen criteria and Ki67 and uPA/PAI-1 status (P = 0.03). Taken together, our data show discordance among markers in identifying the risk of recurrence, even though each marker may prove to be independently valid. PMID: 28954632
- The different values of the cycling nuclear area major dimension may also be connected with the biological behaviour of the three examined groups. Moreover, the endometrial epithelial cells may follow a Ki-67 increase pathway, instead of the relatively stable pathway which the rapidly proliferating adenocarcinoma cells may use. PMID: 28737230
- Age-associated expression of the proliferation and immature neuron markers MKI67 and DCX, respectively, was unrelated, suggesting that neurogenesis-associated processes are independently altered at these points in the development from stem cell to neuron. PMID: 28766905
- High Ki-67 expression in localized PCa is a factor of poor prognosis for prostate cancer PMID: 28648414
- Dual p16 and Ki-67 expression can be used in cervical screening of HPV-positive women. PMID: 29566392
- The expression of alpha-enolase, Ki67 and p53 in pancreatic cancer and adjacent normal tissues were evaluated by IHC using the corresponding primary antibodies on the commercial tissue arrays PMID: 28824297
- All cases of DF showed much higher Ki67 proliferation index (P = 0.0001) along with increased mitotic figures both on H&E and with anti-PHH3 PMID: 28609344
- We performed immunohistochemistry for Ki67, p16INK4a, and WNT5A in human HPs ( hyperplastic polyps), sessile serrated adenomas/polyps (SSA/Ps), and traditional serrated adenomas (TSAs) .The distribution of Ki67 and p16INK4a positive cells in TSAs was different from that in HPs and SSA/Ps. PMID: 28627675
- Ki-67 expression in ureteroscopic biopsy specimens is potentially helpful in clinical decision making for patients with suspected upper urinary tract urothelial carcinoma. PMID: 28554752
- For patients with ER+/HER2- breast cancer, three distinct risk patterns by Ki67-LI levels were confirmed according to the 2015 St Gallen consensus. For patients with clearly low or high Ki67-LI, straightforward clinical decisions could be offered, but for patients with intermediate Ki67-LI, other factors might provide valuable information. PMID: 28061893
- Data suggest that Ki-67 index and survivin may be useful biomarkers for rectal cancer with preoperative chemoradiotherapy. PMID: 29491110
- IHC based post-Ki67 levels may have distinct predictive power compared with the naive IHC Ki67. PMID: 28412725
- Ten international pathology institutions participated in this study and determined messenger RNA expression levels of ERBB2, ESR1, PGR, and MKI67 in both centrally and locally extracted RNA from formalin-fixed, paraffin-embedded breast cancer specimens with the MammaTyper(R) test. Samples were measured repeatedly on different days within the local laboratories, and reproducibility was assessed by means of variance comp... PMID: 28490348
- Our data support Ki67 evaluation to estimate non-small-cell lung cancer (NSCLC) patients' prognosis, particularly for adenocarcinoma. PMID: 26272457
- p16/Ki-67 co-expressions associated strongly with high-risk human papillomavirus persistence, especially with HPV16/18, and could be considered as a suitable biomarker for cervical cancer screening PMID: 27588487
- high expression of VEGF and Ki-67 were independent poor prognostic factors for overall survival in adenoid cystic carcinoma PMID: 26194375
- Proliferative markers-mitotic count and Ki67 index-have limited value to predict recurrence or metastasis in congenital mesoblastic nephromas with a cellular component PMID: 27484189
- KI-67 expression correlates with SATB1 expression in non-small cell lung carcinoma. PMID: 29374696
- Ki-67 may be of diagnostic value in distinguishing between partial and complete hydatidiform moles PMID: 29374747
- Ki-67 proliferation index (P = 0.027) proved to be independent prognostic factors PMID: 27049832
顯示更多
收起更多
-
亞細胞定位:Chromosome. Nucleus. Nucleus, nucleolus.
-
數據庫鏈接:
Most popular with customers
-
-
YWHAB Recombinant Monoclonal Antibody
Applications: ELISA, WB, IHC, IF, FC
Species Reactivity: Human, Mouse, Rat
-
-
-
-
-
-